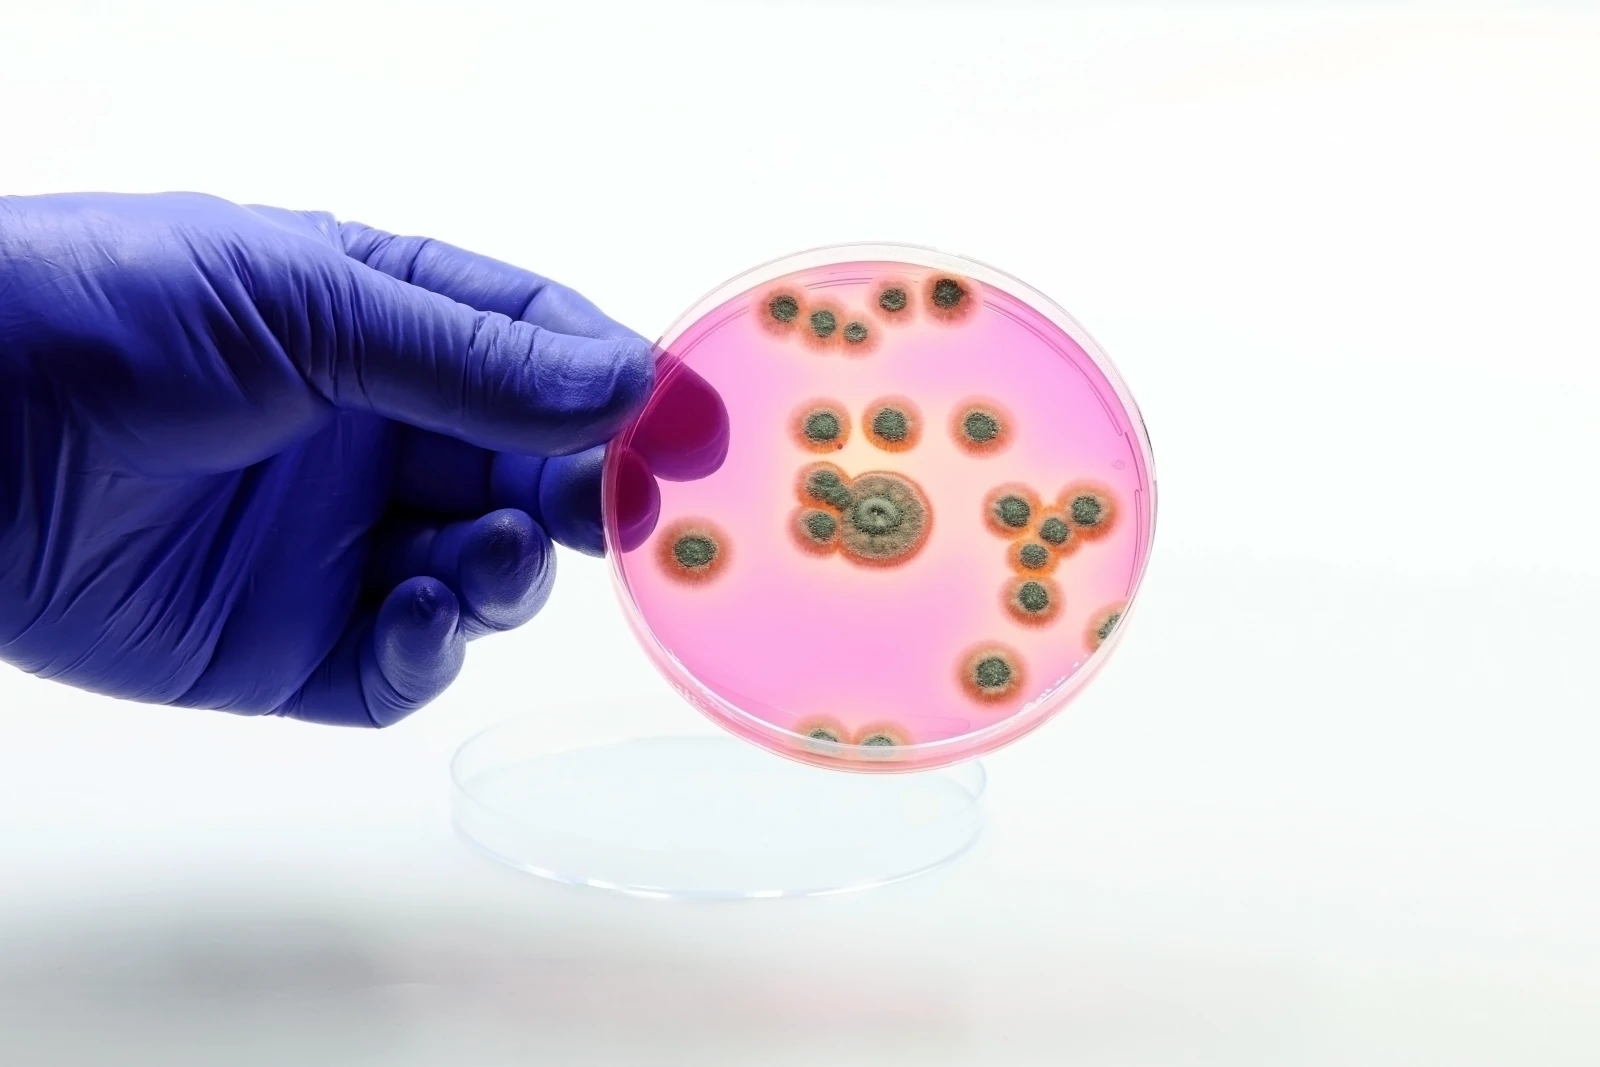

Medical Research Library
Why a medical research library?
The intent behind this medical research library is to build a resource for our patients to access health related articles, clinical trial data. We intend to provide unbiased data that presents legitimate data on diseases, health concerns and the like without the bias of big pharma and the co-oped media. We also will provide data that is often contrary to the media narrative so that you can make informed decisions on health matters for you and your family.
In addition, we will archive all content from our newsletters in this area. At any time, feel free to contact us through our contact form or email office@thedarlingcenter.com.
An excellent article naming the best herbs and supplements for memory loss. Read more about Integrative Medicine here: Integrative Medicine
Eating Healthy is an essential part of Integrative Medicine and research shows that High-Fructose Corn Syrup affects brain health. Read more about Integrative Medicine here: Integrative Medicine
For video content we recommend visit our YouTube channel.
To return to main content select your subject from the menu bar or click here to return to the main page.